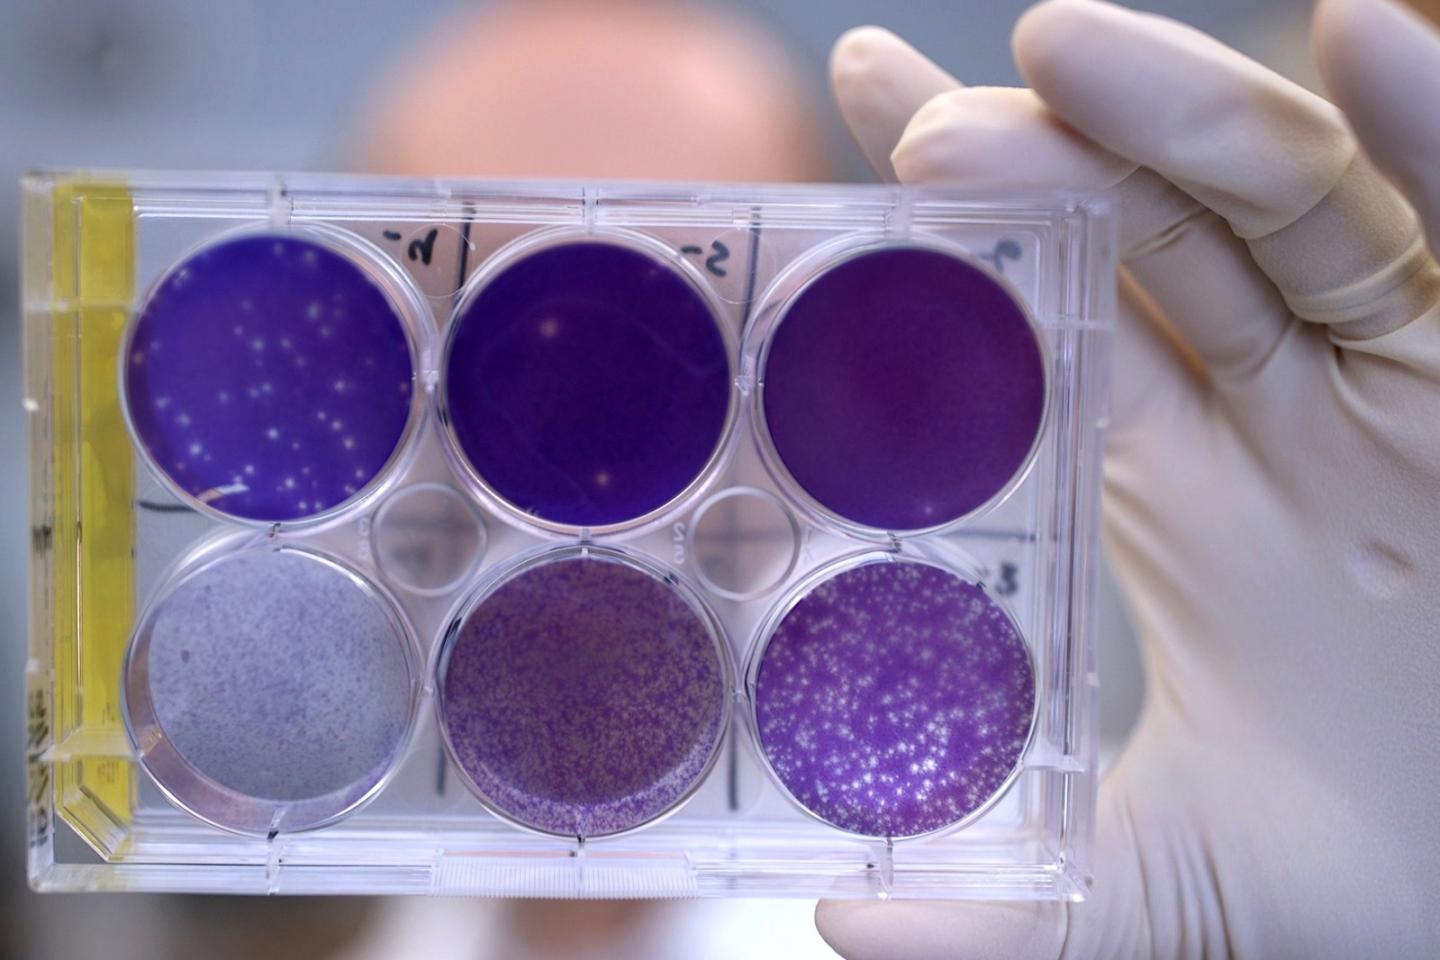

寨卡病毒感染最严重时会导致子宫内感染的婴儿小头畸形或者异常的小脑袋。现今,位于圣路易斯州华盛顿大学医学院和范德堡大学医学院的研究人员已经确认在妊娠期小鼠体内应用人类抗体可以预防胎儿感染寨卡病毒和胎盘损害!该抗体同样可以保护成年小鼠免受寨卡病毒疾病。 Michael Diamond是病理学和医学博士,Herbert S.Gasser的医学教授以及这项研究的共同通讯作者。他说:“这是已经证实的在妊娠期可有效保护胎儿免受寨卡病毒感染的第一种抗病毒药物。”“这也证明了在妊娠期内寨卡病毒是可以治疗的,并且我们已经研究出了一种人类抗体来治疗这种病毒,至少在老鼠身上是有效的。” 这项研究发表在十一月七日出版的《自然》杂志上,作为一种快速跟踪在线发布。 Diamond和共同通讯作者James Crowe Jr(范德堡大学医学院的病理学博士),以及研究组同事们从感染寨卡病毒后痊愈的人体内筛选出29个抗寨卡病毒抗体。他们发现了一种被命名为ZIKV-117的抗体,它可以有效中和实验室里五种寨卡病毒株,这些病毒株代表了该病毒全球范围内的多样性。 为了检测该抗体是否也能保护活体动物,研究人员将其应用到感染寨卡病毒前一天或者感染病毒一天后的妊娠期小鼠体内。在上述两种实验方案中,相对于没有获得该抗体的妊娠期小鼠,抗体治疗能显著降低怀孕母鼠以及胎儿体内的病毒水平,而且在胎盘内也同样有效。 Crowe说:“从人体内分离得到的这些自然产生的抗体代表第一级医学干预,它能够切断寨卡病毒的感染,防止胎儿损伤。” 经抗体治疗的母鼠胎盘显示正常、健康的结构,而未经治疗的母鼠胎盘显示出胎盘结构遭到破坏。人类寨卡病毒感染引起的胎盘破坏可以导致胎儿发育迟缓,甚至可能引起胎儿死亡。 Indira Mysorekar是该研究的共同作者,华盛顿大学医学部妇产科学、病理学与免疫学研究室副教授,生殖科学中心主任。他指出:“我们在经抗体治疗的小鼠胎儿上并没有看到病毒对任何胎儿血管的损伤、胎盘的变薄,或者是任何生长受限问题。抗寨卡病毒抗体通过阻断病毒穿过胎盘,从而保护胎儿免受损害。” 该抗体同样也能保护成年雄性小鼠抵抗致死剂量的寨卡病毒感染,即使在最初感染后的五天。寨卡病毒对人类一般不具有致命性,因此科学家可以应用致死剂量的病毒来观察在最强感染条件下,抗体是如何起效的。 另一位病理学、免疫学以及分子微生物学的教授Diamond说:“我们试图利用高致病性寨卡病毒株来反驳自己的结论,但是即使在这种情况下,抗体仍能对小鼠起到保护作用。” 这些发现说明抗体能够保护成年人和胎儿免受寨卡病毒感染。另外他们认为:从女性体内获得保护性抗体的疫苗也可以对已经怀孕或将要怀孕的女性起到保护胎儿的作用。有一种疫苗已经在人体上进行了试验,但还没有在怀孕的动物上进行测试,所以这项新研究强有力地证明了能在成年人体内产生保护性抗体的疫苗也可能对胎儿起保护作用。 寨卡病毒疫苗可能是最便宜和最简单的预防寨卡病毒相关新生儿缺陷的方法。然而,仍然还有一种极端的可能性,寨卡病毒疫苗能使寨卡病毒感染晚期的病人症状变得更加糟糕。这种现象在登革热病毒感染过程也会出现,登革热病毒是一种与寨卡病毒具有密切关联的病毒。那些已经具有某种登革热病毒毒株抗体的人,与那些没有该类抗体的人相比,在第二种登革热病毒毒株感染时病情会更加严重。这种现象被称为“抗体依赖性增强”,在含有寨卡病毒的培养皿中已经被观察到,但是在活体动物或者在寨卡病毒流行地区的被调查人群中从来没有发现过。 尽管如此,研究人员需要试验他们是否能够通过修改抗体,阻止抗体参与,从而避免寨卡病毒感染时抗体依赖性增强。他们表示:修改后的抗体与原始抗体对胎盘与胎儿的保护起到相同的效果。 在人类疫苗可用之前,为防止母亲将病毒传播给胎儿可以给孕妇注射抗体来保护胎儿。在这种情况之下,生活在寨卡病毒流行地区的妇女在她妊娠期间就可获得该抗体,无论她是否被诊断为感染寨卡病毒,在她第一次得知怀孕时就可获得该抗体。另外,孕妇或者患有急性感染的伴侣都可以用抗体治疗。 Crowe正在继续研发抗体,作为一种潜在的治疗方法,并加紧生产, 为抗体应用于人类研究打下基础。在此期间,Diamond正致力于研究抗体是否可以被用来清除持续性病毒感染。与此同时,他们与其他研究人员携手合作想要更加清楚地理解ZIKV-117是如何与病毒结合并阻止感染的。 Diamond说:“寨卡病毒可以在身体的某些部位存留,如眼睛和睾丸,在那里它可以引起长期的损害,至少在小鼠体内是这样的。这种抗体可以阻止该疾病,现在我们想知道它是否能清除体内那些部位的持续性感染。”原文链接:https://www.eurekalert.org/pub_releases/2016-11/wuso-apd110216.php